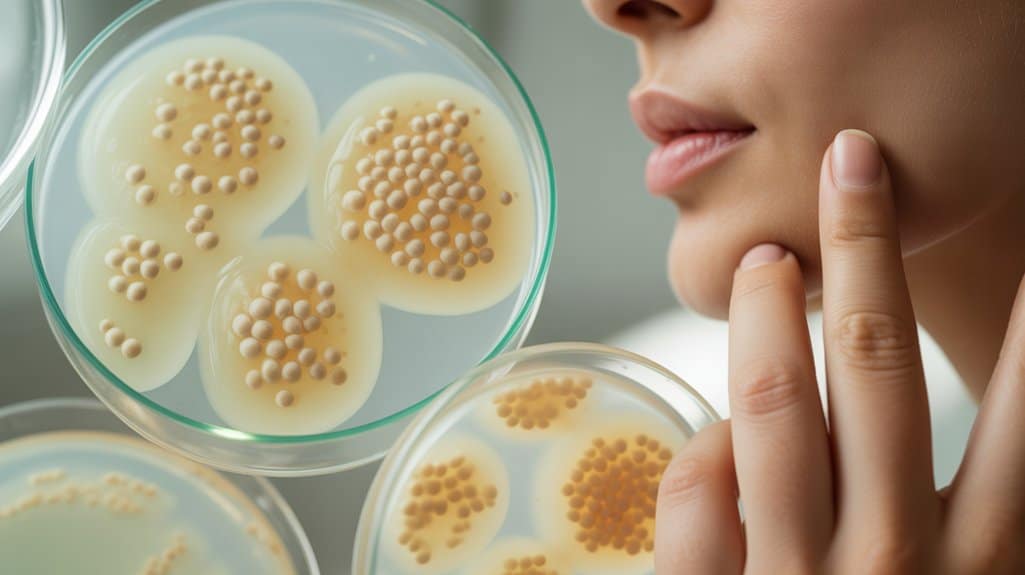
realistische Erwartungen für Probiotika

Zuletzt aktualisiert am 10. Dezember 2025 von Gesundheitsticker
Viele Menschen fragen sich, ob das, was in ihrem Körper passiert, beeinflussen könnte, was sich auf ihrem Gesicht zeigt. Wissenschaftler haben diese Verbindung seit Jahren erforscht und sie haben etwas Interessantes entdeckt. Der Darm scheint die Hautgesundheit mehr zu beeinflussen, als irgendjemand erwartet hatte. Probiotika—diese freundlichen Bakterien, die oft in Joghurt zu finden sind—könnten einen neuen Weg zu klarerer, ruhigerer Haut bieten. Dieser Ansatz funktioniert anders als herkömmliche Cremes und Behandlungen, was eine wichtige Frage aufwirft: könnte das Ausbalancieren der inneren Gesundheit das fehlende Puzzleteil sein?
Was die Forschung über Probiotika und Hautgesundheit enthüllt

Eine neue Überprüfung wissenschaftlicher Studien bietet ermutigende Nachrichten für alle, die hoffen, dass ihre täglichen Probiotika mehr bewirken könnten als nur die Verdauung zu unterstützen. Forscher untersuchten neun randomisierte Studien und fanden heraus, dass orale Probiotika-Quellen dabei halfen, Hautgesundheit und -klarheit zu verbessern. Die Verbindung zwischen Darmgesundheit und Teint überraschte viele Teilnehmer. Wissenschaftler glauben, dass Probiotika wirken, indem sie Entzündungen im ganzen Körper reduzieren, was dann das Hautmikrobiom unterstützt und schützende Barrieren stärkt. Jedoch erweist sich Geduld als wesentlich—die meisten Personen bemerkten Verbesserungen erst nach zwölf Wochen konsequenter Anwendung. Frühe Begeisterung kann schwinden, wenn Ergebnisse nicht sofort erscheinen, aber Beharrlichkeit belohnt oft diejenigen, die bereit sind zu warten.
Wie Probiotika wirken, um Ihre Haut zu verbessern
Das Verständnis, dass Probiotika die Hautgesundheit unterstützen, führt natürlich zu der Frage, wie sie dies tatsächlich bewerkstelligen. Die Verbindung erfolgt über Ihr Darmmikrobiom. Wenn Sie Probiotika einnehmen, helfen sie dabei, die nützlichen Bakterien in Ihrem Verdauungssystem auszugleichen. Dieses Gleichgewicht ist wichtig, weil ein gesünderer Darm weniger Hautentzündungen in Ihrem ganzen Körper bedeutet.
| Was passiert | Wie es Ihrer Haut hilft |
|---|---|
| Reduziert Entzündungen | Beruhigt Rötungen und Ausbrüche |
| Stärkt die Darmbarriere | Verbessert die Hautbarrierefunktion |
| Gleicht die Immunantwort aus | Verringert Akne-Auslöser |
Stellen Sie es sich als Dominoeffekt vor, der in Ihrem Körper beginnt und Ergebnisse auf der Außenseite zeigt.
Verständnis der Unterschiede von Probiotikastämmen
Vier Hauptgruppen von Probiotika-Familien tauchten in den neuesten Hautgesundheitsstudien auf. Lactobacillus, Bifidobacterium, Bacillus und Enterococcus erschienen alle in verschiedenen Forschungsprojekten. Jede hat einzigartige probiotische Ursprünge und Eigenschaften.
Hier ist der Haken: Wissenschaftler haben noch nicht herausgefunden, welche Stämme am besten wirken. Die Studien verwendeten verschiedene Kombinationen, was es schwierig macht, die Stammwirksamkeit zu vergleichen. Es ist, als würde man versuchen, das perfekte Rezept zu finden, wenn jeder verschiedene Zutaten verwendet.
Im Moment gibt es kein einzelnes „bestes“ Probiotikum für reinere Haut. Forscher arbeiten noch daran zu verstehen, welche Stämme die stärksten Ergebnisse liefern. Das bedeutet, wir lernen alle gemeinsam darüber, was wirklich hilft.
Wie man Probiotika zur Aknebehandlung verwendet
Beim Hinzufügen von Probiotika zu einer Akne-Behandlungsroutine sind Timing und Erwartungen am wichtigsten. Diese hilfreichen Bakterien wirken am besten zusammen mit regulären Hautpflegemethoden wie Retinoiden oder Benzoylperoxid. Sie sind keine Wundermittel, aber sie können über die Zeit sanfte Unterstützung bieten.
| Aspekt | Empfehlung |
|---|---|
| Probiotika-Dosierung | Anweisungen auf dem Etikett befolgen |
| Zeit bis Ergebnisse sichtbar werden | Mindestens 12 Wochen |
| Verwendung mit anderen Behandlungen | Ja, als Ergänzung |
| Erwartete Wirkung | Kleine, schrittweise Verbesserungen |
| Bester Ansatz | Geduldig und beständig bleiben |
Realistische Erwartungen für Probiotika-Vorteile setzen
Warum schwören manche Menschen auf Probiotika für ihre Haut, während andere überhaupt keine Veränderung sehen? Die Antwort liegt oft in realistischen Zeitplänen und Geduld. Die meisten Menschen werden in den ersten Monaten keine Unterschiede bemerken. Forschungen zeigen, dass Vorteile typischerweise nach drei Monaten konsequenter Anwendung auftreten. Dieser schrittweise Fortschritt kann sich langsam anfühlen, aber er spiegelt wider, wie die Darmgesundheit allmählich die Haut beeinflusst. Denken Sie an Probiotika als sanfte Unterstützung, nicht als schnelle Lösung. Sie arbeiten zusammen mit Ihrer regulären Hautpflegeroutine und schaffen subtile Verbesserungen über die Zeit. Für diejenigen in unserer Gemeinschaft, die diesen Ansatz ausprobieren, denken Sie daran: geben Sie ihm mindestens zwölf Wochen, bevor Sie entscheiden, ob es hilft.







